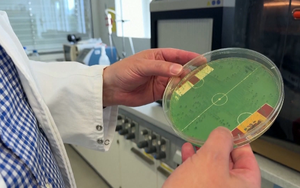
Vi khuẩn E.coli dự đoán Tây Ban Nha vô địch EURO 2024

Tây Ban Nha là đội bóng mạnh nhất thế giới
Tây Ban Nha đi vào lịch sử với tư cách là đội đầu tiên giành 4 chức vô địch EURO và HLV Luis de la Fuente tuyên bố, họ đang là đội bóng mạnh nhất thế giới.
Rodri: Người hùng thầm lặng
Không ồn ào, không gây sự chú ý nhưng Rodri có sự đóng góp rất đặc biệt và là người hùng của Tây ban Nha trong hành trình kiến tạo cột mốc lịch sử với 4 chức vô địch EURO.
Tây Ban Nha vô địch với hành trình phi thường
Kỷ lục 4 lần lên đỉnh châu Âu cùng hành trình giành chức vô địch EURO 2024 cực kỳ ấn tượng của Tây Ban Nha đã đem lại sự tự hào cho các CĐV.
CĐV Tây Ban Nha: 2 năm nữa chúng tôi sẽ vô địch World Cup
Trong niềm vui sướng vỡ òa sau trận chung kết EURO, các CĐV Tây Ban Nha tin rằng với những cầu thủ trẻ như Yamal và Williams, đội nhà sẽ vô địch World Cup tới đây.
Yamal: Niềm tự hào của xóm nghèo Rocafonda
Lamine Yamal kiến tạo nên cột mốc lịch sử của bóng đá thế giới trong niềm tự hào của những người dân nghèo nơi anh và gia đình sinh sống.

CĐV Tây Ban Nha: Đội may mắn hơn sẽ vô địch
Những người Tây Ban Nha sinh sống ở Anh kỳ vọng được chứng kiến một cuộc so tài hấp dẫn và cho rằng đội bóng may mắn hơn sẽ giành chức vô địch EURO 2024.

CĐV Anh và Tây Ban Nha phủ kín Berlin trước trận chung kết EURO 2024
Thủ đô Berlin trở nên sôi động khi rất động CĐV của Anh và Tây Ban Nha tập trung tại đây để tiếp sức cho đội nhà lên ngôi vô địch EURO 2024.

Lịch sử đối đầu ủng hộ tuyển Anh vô địch EURO 2024
Tây Ban Nha được đánh giá cao hơn về kinh nghiệm ở sân chơi lớn, phong độ và cách chơi nhưng lịch sử đối đầu tại EURO cho thấy, tuyển Anh mới là những người biết cách đánh bại đối thủ.

HLV Southgate: Tôi không tin vào cổ tích nhưng tin giấc mơ lớn của Anh sẽ thành hiện thực
HLV Gareth Southgate khẳng định ông không tin vào câu chuyện cổ tích nhưng giấc mơ lớn của tuyển Anh sẽ thành hiện thực tại EURO 2024.

Anh và Tây Ban Nha trước ngưỡng cửa lịch sử
Anh hay Tây Ban Nha giành chiến thắng ở trận chung kết EURO 2024 cũng sẽ kiến tạo nên một cột mốc mới trong lịch sử nền bóng đá của riêng mình.

Sân Olympic đẹp như mơ trước trận chung kết EURO 2024
Trương Anh Ngọc - PV TTXVN tác nghiệp tại Đức có mặt tại SVĐ Olympic ở thủ đô Berlin trước trận chung kết EURO 2024.

HLV Murat Yakin được gia hạn hợp đồng sau EURO 2024
Sau màn trình diễn ấn tượng của đội tuyển Thuỵ Sỹ và vào tứ kết EURO 2024, HLV Murat Yakin đã được gia hạn hợp đồng.

Điểm nóng Rodri - Mainoo: Kinh nghiệm đấu sức trẻ
Điểm nóng nhất trận đấu chung kết giữa Tây Ban Nha và Anh sẽ là khu vực giữa sân, với cuộc đối đầu giữa Rodri bên phía Tây Ban Nha với Mainoo của đội bóng xứ sở sương mù.

Cầu thủ Anh: Chúng tôi sẽ làm nên lịch sử
Declan Rice và Olie Watkins dành sự tôn trọng cho Tây Ban Nha trước trận chung kết EURO 2024 song tự tin sẽ cùng tuyển Anh làm nên lịch sử.
Vi khuẩn E.coli dự đoán Tây Ban Nha vô địch EURO 2024
Nhà tiên tri thể thao độc đáo nhất nước Đức - vi khuẩn E.coli đã dự đoán Tây Ban Nha giành chiến thắng trong trận chung kết Euro 2024.

Đười ươi Walter dự đoán Tây Ban Nha vô địch EURO 2024
Trước trận chung kết Euro 2024 giữa Tây Ban Nha và Anh, chú đười ươi Walter dự đoán Tây Ban Nha sẽ là nhà vô địch châu Âu.

Tuyển Anh mạnh mẽ hơn sau thất bại ở chung kết EURO 2021
HLV Gareth Southgate khẳng định, tuyển Anh mạnh mẽ hơn sau thất bại ở chung kết kỳ EURO 2021 và đã sẵn sàng làm nên lịch sử.

Cầu thủ Tây Ban Nha áp đảo trong đội hình tiêu biểu vòng bán kết EURO 2024
5 chân sút của đội tuyển Tây Ban Nha góp mặt trong đội hình tiêu biểu vòng bán kết EURO 2024 do tạp chí One Football bình chọn.
 Thời tiết
Thời tiết
Hà Nội
-
An Giang
-
Bình Dương
-
Bình Phước
-
Bình Thuận
-
Bình Định
-
Bạc Liêu
-
Bắc Giang
-
Bắc Kạn
-
Bắc Ninh
-
Bến Tre
-
Cao Bằng
-
Cà Mau
-
Cần Thơ
-
Điện Biên
-
Đà Nẵng
-
Đà Lạt
-
Đắk Lắk
-
Đắk Nông
-
Đồng Nai
-
Đồng Tháp
-
Gia Lai
-
Hà Nội
-
TP Hồ Chí Minh
-
Hà Giang
-
Hà Nam
-
Hà Tĩnh
-
Hòa Bình
-
Hưng Yên
-
Hải Dương
-
Hải Phòng
-
Hậu Giang
-
Khánh Hòa
-
Kiên Giang
-
Kon Tum
-
Lai Châu
-
Long An
-
Lào Cai
-
Lâm Đồng
-
Lạng Sơn
-
Nam Định
-
Nghệ An
-
Ninh Bình
-
Ninh Thuận
-
Phú Thọ
-
Phú Yên
-
Quảng Bình
-
Quảng Nam
-
Quảng Ngãi
-
Quảng Ninh
-
Quảng Trị
-
Sóc Trăng
-
Sơn La
-
Thanh Hóa
-
Thái Bình
-
Thái Nguyên
-
Thừa Thiên Huế
-
Tiền Giang
-
Trà Vinh
-
Tuyên Quang
-
Tây Ninh
-
Vĩnh Long
-
Vĩnh Phúc
-
Vũng Tàu
-
Yên Bái







